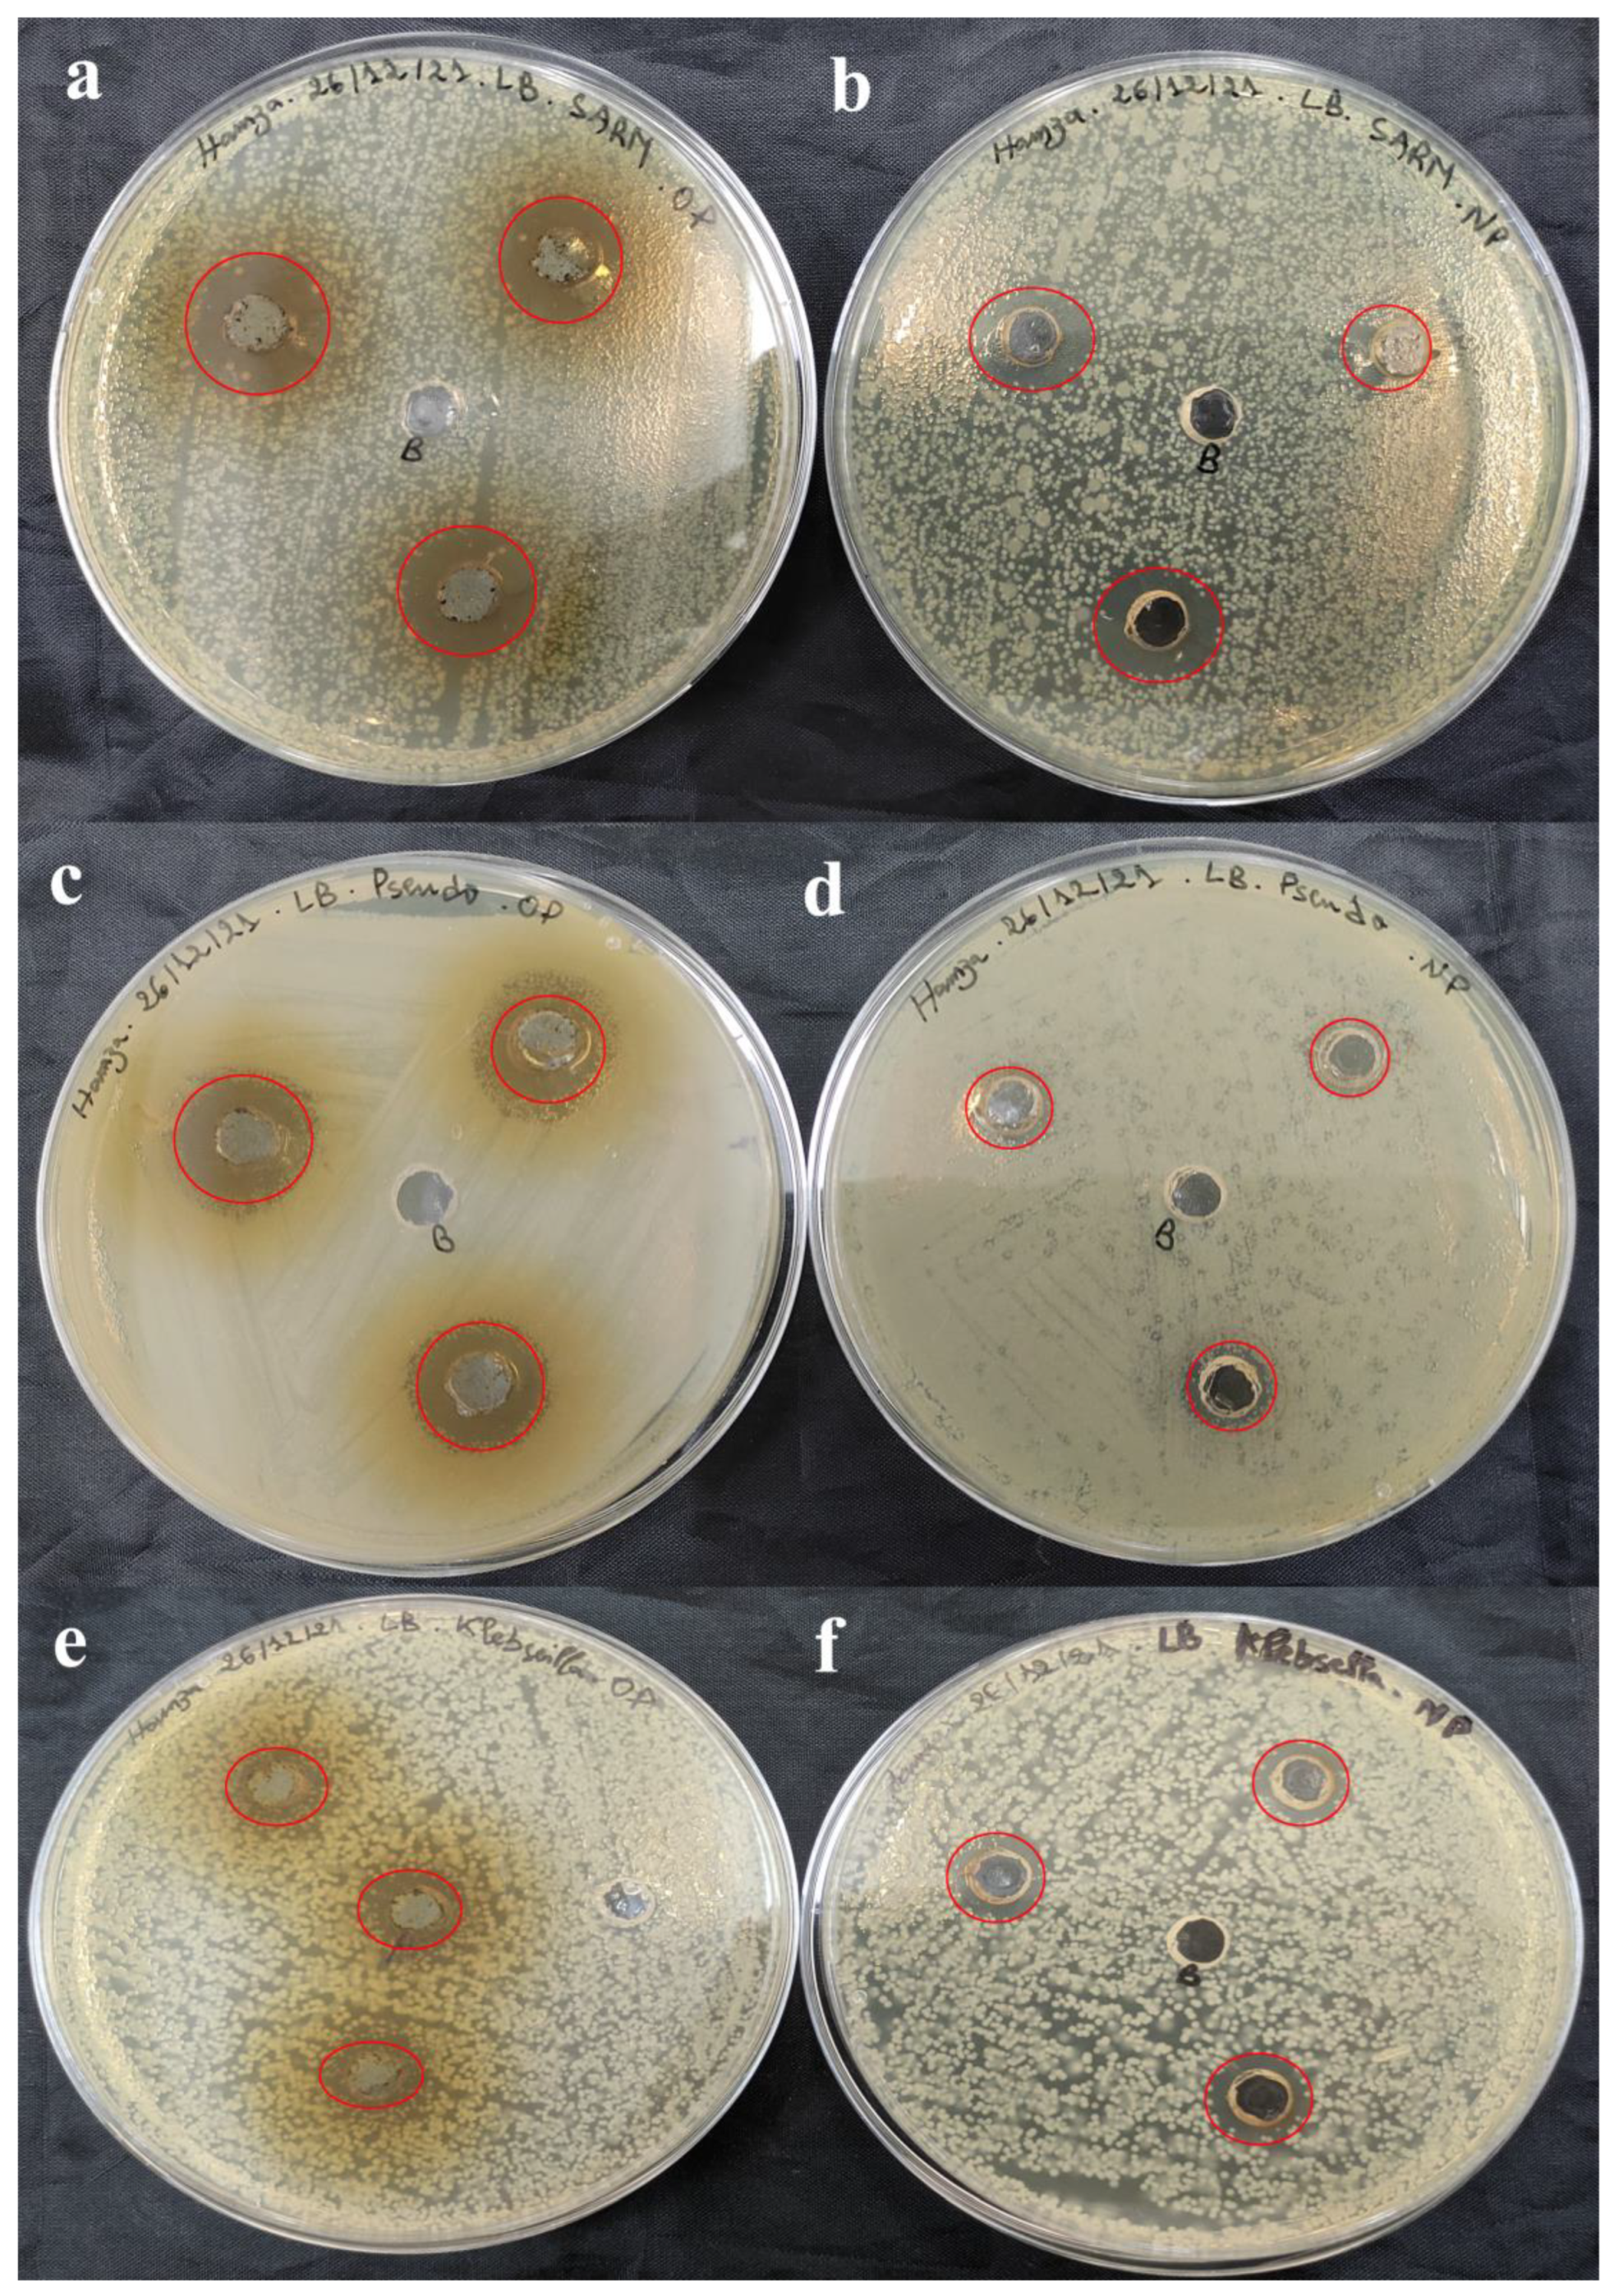
Bioengineering 11 01205 g011

From Green Chemistry to Healthy Environments: Silver Nanoparticles as a Dual Antioxidant and Antibacterial Agents for Advancing Biomedicine and Sustainable Wastewater Treatment
Abstract
1. Introduction
2. Results
2.1. Biosynthesis of AgNPs Using S. officinalis L. Leaves Extract
2.2. Characterization of Green Synthesized SO-AgNPs
2.3. Scavenging Free Radical Activity of Slavia Extract and SO-AgNPs
2.4. Antimicrobial Activity of SO-AgNPs
3. Discussion
4. Materials and Methods
4.1. Materials
4.2. Ultrasound-Assisted Extraction
4.3. Green Synthesis of SO-AgNPs
4.4. Characterization of SO-AgNPs
4.5. Scavenging Free Radical Activity of Salvia Extract and SO-AgNPs
4.6. Antimicrobial Activity of SO-AgNPs and Optimal Extract from S. officinalis L. Against Reference Strains of Bacteria
4.7. Antimicrobial Activity of SO-AgNPs and Optimal Extract from S. officinalis L. Against Strains Bacteria of Industrial Effluent
4.8. Statistical Analyses
5. Conclusions
Author Contributions
Funding
Data Availability Statement
Acknowledgments
Conflicts of Interest
References
- Escarcega-Gonzalez, C.E.; Garza-Cervantes, J.A.; Vazquez-Rodriguez, A.; Montelongo-Peralta, L.Z.; Trevino-Gonzalez, M.T.; Diaz Barriga Castro, E.; Saucedo-Salazar, E.M.; Chavez Morales, R.M.; Regalado Soto, D.I.; Trevino Gonzalez, F.M.; et al. In vivo antimicrobial activity of silver nanoparticles produced via a green chemistry synthesis using Acacia rigidula as a reducing and capping agent. Int. J. Nanomed. 2018, 13, 2349–2363. [Google Scholar] [CrossRef]
- Yin, I.X.; Zhang, J.; Zhao, I.S.; Mei, M.L.; Li, Q.; Chu, C.H. The Antibacterial Mechanism of Silver Nanoparticles and Its Application in Dentistry. Int. J. Nanomed. 2020, 15, 2555–2562. [Google Scholar] [CrossRef]
- Rafique, M.; Sadaf, I.; Rafique, M.S.; Tahir, M.B. A review on green synthesis of silver nanoparticles and their applications. Artif. Cells Nanomed. Biotechnol. 2017, 45, 1272–1291. [Google Scholar] [CrossRef]
- Akdeniz, E.; Yakisik, E.; Rasouli Pirouzian, H.; Akkin, S.; Turan, B.; Tipigil, E.; Toker, O.S.; Ozcan, O. Carob powder as cocoa substitute in milk and dark compound chocolate formulation. J. Food Sci. Technol. 2021, 58, 4558–4566. [Google Scholar] [CrossRef]
- Vijayaram, S.; Ghafarifarsani, H.; Vuppala, S.; Nedaei, S.; Mahendran, K.; Murugappan, R.; Chou, C.-C. Selenium Nanoparticles: Revolutionizing Nutrient Enhancement in Aquaculture—A Review. Biol. Trace Elem. Res. 2024, 1–12. [Google Scholar] [CrossRef]
- Deonas, A.N.; Souza, L.; Andrade, G.J.S.; Germiniani-Cardozo, J.; Dahmer, D.; de Oliveira, A.G.; Nakazato, G.; Torezan, J.M.D.; Kobayashi, R.K.T. Green Synthesis of Silver Nanoparticle from Anadenanthera colubrina Extract and Its Antimicrobial Action against ESKAPEE Group Bacteria. Antibiotics 2024, 13, 777. [Google Scholar] [CrossRef]
- Jeon, Y.N.; Ryu, S.J.; Lee, H.Y.; Kim, J.O.; Baek, J.S. Green Synthesis of Silver Nanoparticle Using Black Mulberry and Characterization, Phytochemical, and Bioactivity. Antibiotics 2024, 13, 686. [Google Scholar] [CrossRef] [PubMed]
- Loo, Y.Y.; Rukayadi, Y.; Nor-Khaizura, M.A.; Kuan, C.H.; Chieng, B.W.; Nishibuchi, M.; Radu, S. In Vitro Antimicrobial Activity of Green Synthesized Silver Nanoparticles Against Selected Gram-negative Foodborne Pathogens. Front. Microbiol. 2018, 9, 1555. [Google Scholar] [CrossRef] [PubMed]
- Tormena, R.P.I.; Rosa, E.V.; Mota, B.d.F.O.; Chaker, J.A.; Fagg, C.W.; Freire, D.O.; Martins, P.M.; da Silva, I.C.R.; Sousa, M.H. Evaluation of the antimicrobial activity of silver nanoparticles obtained by microwave-assisted green synthesis using Handroanthus impetiginosus (Mart. ex DC.) Mattos underbark extract. RSC Adv. 2020, 10, 20676–20681. [Google Scholar] [CrossRef] [PubMed]
- Bharadwaj, K.K.; Rabha, B.; Pati, S.; Choudhury, B.K.; Sarkar, T.; Gogoi, S.K.; Kakati, N.; Baishya, D.; Kari, Z.A.; Edinur, H.A. Green Synthesis of Silver Nanoparticles Using Diospyros malabarica Fruit Extract and Assessments of Their Antimicrobial, Anticancer and Catalytic Reduction of 4-Nitrophenol (4-NP). Nanomaterials 2021, 11, 1999. [Google Scholar] [CrossRef] [PubMed]
- Ma, Z.; Liu, J.; Liu, Y.; Zheng, X.; Tang, K. Green synthesis of silver nanoparticles using soluble soybean polysaccharide and their application in antibacterial coatings. Int. J. Biol. Macromol. 2021, 166, 567–577. [Google Scholar] [CrossRef] [PubMed]
- Morales-Lozoya, V.; Espinoza-Gómez, H.; Flores-López, L.Z.; Sotelo-Barrera, E.L.; Núñez-Rivera, A.; Cadena-Nava, R.D.; Alonso-Nuñez, G.; Rivero, I.A. Study of the effect of the different parts of Morinda citrifolia L. (noni) on the green synthesis of silver nanoparticles and their antibacterial activity. Appl. Surf. Sci. 2021, 537, 147855. [Google Scholar] [CrossRef]
- Li, H.; Yang, Z.; Khan, S.A.; Walsh, L.J.; Seneviratne, C.J.; Ziora, Z.M. Characteristics of Metallic Nanoparticles (Especially Silver Nanoparticles) as Anti-Biofilm Agents. Antibiotics 2024, 13, 819. [Google Scholar] [CrossRef]
- Takcı, D.K.; Ozdenefe, M.S.; Genc, S. Green synthesis of silver nanoparticles with an antibacterial activity using Salvia officinalis aqueous extract. J. Cryst. Growth 2023, 614, 127239. [Google Scholar] [CrossRef]
- Saud, M.; Saud, N.; Hamad, M.; Farhan Gar, L. Role of Salvia officinalis silver nanoparticles in attenuation renal damage in rabbits exposed to methotrexate. Arch. Razi Inst. 2022, 77, 151. [Google Scholar]
- Sharifi, F.; Sharififar, F.; Soltanian, S.; Doostmohammadi, M.; Mohamadi, N. Synthesis of silver nanoparticles using Salvia officinalis extract: Structural characterization, cytotoxicity, antileishmanial and antimicrobial activity. Nanomed. Res. J. 2020, 5, 339–346. [Google Scholar]
- Moussa, H.; Dahmoune, F.; Mahdjoub, M.m.; Kadri, N.; Remini, H. Definitive screening design and I-optimal design for optimization of ultrasound-assisted extraction of phenolic content and antioxidant capacity from Salvia officinalis L. leaves. Sustain. Chem. Pharm. 2022, 29, 100820. [Google Scholar] [CrossRef]
- Moussa, H.; Dahmoune, F.; Mróz, M.; Remini, H.; Kadri, N.; Hamid, S.; Kusznierewicz, B. Efficient optimization approaches for microwave assisted extraction of high-quality antioxidant compounds from Salvia officinalis L.: UHPLC-HRMS differential analysis of phenolic profiles obtained by ultrasound and microwave extraction. Sustain. Chem. Pharm. 2023, 35, 101194. [Google Scholar] [CrossRef]
- Khane, Y.; Benouis, K.; Albukhaty, S.; Sulaiman, G.M.; Abomughaid, M.M.; Al Ali, A.; Aouf, D.; Fenniche, F.; Khane, S.; Chaibi, W.; et al. Green Synthesis of Silver Nanoparticles Using Aqueous Citrus limon Zest Extract: Characterization and Evaluation of Their Antioxidant and Antimicrobial Properties. Nanomaterials 2022, 12, 2013. [Google Scholar] [CrossRef] [PubMed]
- Garibo, D.; Borbon-Nunez, H.A.; de Leon, J.N.D.; Garcia Mendoza, E.; Estrada, I.; Toledano-Magana, Y.; Tiznado, H.; Ovalle-Marroquin, M.; Soto-Ramos, A.G.; Blanco, A.; et al. Green synthesis of silver nanoparticles using Lysiloma acapulcensis exhibit high-antimicrobial activity. Sci. Rep. 2020, 10, 12805. [Google Scholar] [CrossRef] [PubMed]
- Oves, M.; Ahmar Rauf, M.; Aslam, M.; Qari, H.A.; Sonbol, H.; Ahmad, I.; Sarwar Zaman, G.; Saeed, M. Green synthesis of silver nanoparticles by Conocarpus Lancifolius plant extract and their antimicrobial and anticancer activities. Saudi J. Biol. Sci. 2022, 29, 460–471. [Google Scholar] [CrossRef] [PubMed]
- Thompson, A.; Meah, D.; Ahmed, N.; Conniff-Jenkins, R.; Chileshe, E.; Phillips, C.O.; Claypole, T.C.; Forman, D.W.; Row, P.E. Comparison of the antibacterial activity of essential oils and extracts of medicinal and culinary herbs to investigate potential new treatments for irritable bowel syndrome. BMC Complement. Altern. Med. 2013, 13, 338. [Google Scholar] [CrossRef] [PubMed]
- Hayat, P.; Khan, I.; Rehman, A.; Jamil, T.; Hayat, A.; Rehman, M.U.; Ullah, N.; Sarwar, A.; Alharbi, A.A.; Dablool, A.S.; et al. Myogenesis and Analysis of Antimicrobial Potential of Silver Nanoparticles (AgNPs) against Pathogenic Bacteria. Molecules 2023, 28, 637. [Google Scholar] [CrossRef] [PubMed]
- Qais, F.A.; Shafiq, A.; Khan, H.M.; Husain, F.M.; Khan, R.A.; Alenazi, B.; Alsalme, A.; Ahmad, I. Antibacterial Effect of Silver Nanoparticles Synthesized Using Murraya koenigii (L.) against Multidrug-Resistant Pathogens. Bioinorg. Chem. Appl. 2019, 2019, 4649506. [Google Scholar] [CrossRef] [PubMed]
- Hemlata; Meena, P.R.; Singh, A.P.; Tejavath, K.K. Biosynthesis of Silver Nanoparticles Using Cucumis prophetarum Aqueous Leaf Extract and Their Antibacterial and Antiproliferative Activity Against Cancer Cell Lines. ACS Omega 2020, 5, 5520–5528. [Google Scholar] [CrossRef] [PubMed]
- Aboelfetoh, E.F.; El-Shenody, R.A.; Ghobara, M.M. Eco-friendly synthesis of silver nanoparticles using green algae (Caulerpa serrulata): Reaction optimization, catalytic and antibacterial activities. Environ. Monit. Assess. 2017, 189, 349. [Google Scholar] [CrossRef] [PubMed]
- Chugh, D.; Viswamalya, V.S.; Das, B. Green synthesis of silver nanoparticles with algae and the importance of capping agents in the process. J. Genet. Eng. Biotechnol. 2021, 19, 126. [Google Scholar] [CrossRef]
- Balciunaitiene, A.; Januskevice, V.; Saunoriute, S.; Raubyte, U.; Viskelis, J.; Memvanga, P.B.; Viskelis, P. Antimicrobial Antioxidant Polymer Films with Green Silver Nanoparticles from Symphyti radix. Polymers 2024, 16, 317. [Google Scholar] [CrossRef] [PubMed]
- Altuwaijri, Y.A.; Alshiekheid, M.A.; Aldosari, N.S.; Alghamdi, M.A.; Moubayed, N.M.S. Enhancing antibacterial activity through green synthesis of silver nanoparticles with Salvia officinalis extracts. Int. J. Adv. Appl. Sci. 2024, 11, 19–23. [Google Scholar] [CrossRef]
- Balciunaitiene, A.; Liaudanskas, M.; Puzeryte, V.; Viskelis, J.; Janulis, V.; Viskelis, P.; Griskonis, E.; Jankauskaite, V. Eucalyptus globulus and Salvia officinalis Extracts Mediated Green Synthesis of Silver Nanoparticles and Their Application as an Antioxidant and Antimicrobial Agent. Plants 2022, 11, 1085. [Google Scholar] [CrossRef] [PubMed]
- Jamil, Y.M.S.; Al-Hakimi, A.N.; Al-Maydama, H.M.A.; Almahwiti, G.Y.; Qasem, A.; Saleh, S.M.; Pasupuleti, K.S. Optimum Green Synthesis, Characterization, and Antibacterial Activity of Silver Nanoparticles Prepared from an Extract of Aloe fleurentinorum. Int. J. Chem. Eng. 2024, 2024, 2804165. [Google Scholar] [CrossRef]
- Balciunaitiene, A.; Puzeryte, V.; Radenkovs, V.; Krasnova, I.; Memvanga, P.B.; Viskelis, P.; Streimikyte, P.; Viskelis, J. Sustainable-Green Synthesis of Silver Nanoparticles Using Aqueous Hyssopus officinalis and Calendula officinalis Extracts and Their Antioxidant and Antibacterial Activities. Molecules 2022, 27, 7700. [Google Scholar] [CrossRef] [PubMed]
- Khalandi, B.; Asadi, N.; Milani, M.; Davaran, S.; Abadi, A.J.; Abasi, E.; Akbarzadeh, A. A Review on Potential Role of Silver Nanoparticles and Possible Mechanisms of their Actions on Bacteria. Drug Res. 2017, 67, 70–76. [Google Scholar] [CrossRef]
- Qing, Y.; Cheng, L.; Li, R.; Liu, G.; Zhang, Y.; Tang, X.; Wang, J.; Liu, H.; Qin, Y. Potential antibacterial mechanism of silver nanoparticles and the optimization of orthopedic implants by advanced modification technologies. Int. J. Nanomed. 2018, 13, 3311–3327. [Google Scholar] [CrossRef] [PubMed]
- Prabhu, S.; Poulose, E.K. Silver nanoparticles: Mechanism of antimicrobial action, synthesis, medical applications, and toxicity effects. Int. Nano Lett. 2012, 2, 32. [Google Scholar] [CrossRef]
- Kebir, M.; Tahraoui, H.; Chabani, M.; Trari, M.; Noureddine, N.; Assadi, A.A.; Amrane, A.; Ben Hamadi, N.; Khezami, L. Water Cleaning by a Continuous Fixed-Bed Column for Cr(VI) Eco-Adsorption with Green Adsorbent-Based Biomass: An Experimental Modeling Study. Processes 2023, 11, 363. [Google Scholar] [CrossRef]
- Madi, K.; Chebli, D.; Ait Youcef, H.; Tahraoui, H.; Bouguettoucha, A.; Kebir, M.; Zhang, J.; Amrane, A. Green Fabrication of ZnO Nanoparticles and ZnO/rGO Nanocomposites from Algerian Date Syrup Extract: Synthesis, Characterization, and Augmented Photocatalytic Efficiency in Methylene Blue Degradation. Catalysts 2024, 14, 62. [Google Scholar] [CrossRef]
- Hamid, S.; Oukil, N.F.; Moussa, H.; Djihad, N.; Mróz, M.; Kusznierewicz, B.; Attia, A.; Djenadi, K.; Mahdjoub, M.M.; Bouhenna, M.M.; et al. Chemical and biological characterization of Ocimum basilicum L. phenolic extract and essential oil derived through ultrasound and microwave-assisted extraction techniques. Food Biosci. 2024, 60, 104359. [Google Scholar] [CrossRef]
- Smara, M.; Khalladi, R.; Moulai-Mostefa, N.; Madi, K.; Mansour, D.; Lekmine, S.; Benslama, O.; Tahraoui, H.; Zhang, J.; Amrane, A. Efficiency of Hydrogen Peroxide and Fenton Reagent for Polycyclic Aromatic Hydrocarbon Degradation in Contaminated Soil: Insights from Experimental and Predictive Modeling. Processes 2024, 12, 621. [Google Scholar] [CrossRef]
- Fahmy, N.M.; Fayez, S.; Zengin, G.; Selvi, S.; Uba, A.I.; Mollica, A.; Bouyahya, A.; Ponniya, S.K.M.; Nilofar; Lekmine, S. Chemical Exploration of Different Extracts from Phytolacca americana Leaves and Their Potential Utilization for Global Health Problems: In Silico and Network Pharmacology Validation. J. Biomol. Struct. Dyn. 2024, 1–21. [Google Scholar] [CrossRef] [PubMed]
- Lekmine, S.; Benslama, O.; Kadi, K.; Martín-García, A.I.; Ola, M.S.; Yilmaz, M.A.; Ali, A. Therapeutic Potential of Hyoscyamus Niger-Derived Compounds: Targeting Ovarian Cancer through Antioxidant Activity and EGFR Tyrosine Kinase Inhibition. J. King Saud. Univ.-Sci. 2024, 36, 103103. [Google Scholar] [CrossRef]
- Triki, Z.; Fergani, Z.; Lekmine, S.; Tahraoui, H.; Amrane, A.; Zamouche, M.; Kebir, M.; Assadi, A.A.; Khezami, L.; Zhang, J. Numerical Modelling and Performance Evaluation of Vacuum Membrane Distillation for Energy-Efficient Seawater Desalination: Towards Energy-Efficient Solutions. Water 2023, 15, 3612. [Google Scholar] [CrossRef]
- Lekmine, S.; Benslama, O.; Tahraoui, H.; Ola, M.S.; Laouani, A.; Kadi, K.; Martín-García, A.I.; Ali, A. Anti-Cholinergic Effects of the Phenolic Extract from the Astragalus Crenatus Plant: A Computational and Network Pharmacology Study. Pharmaceuticals 2024, 17, 348. [Google Scholar] [CrossRef]
- Yahoum, M.M.; Toumi, S.; Tahraoui, H.; Lefnaoui, S.; Kebir, M.; Amrane, A.; Assadi, A.A.; Zhang, J.; Mouni, L. Formulation and Evaluation of Xanthan Gum Microspheres for the Sustained Release of Metformin Hydrochloride. Micromachines 2023, 14, 609. [Google Scholar] [CrossRef] [PubMed]
- Sid, A.N.E.H.; Tahraoui, H.; Kebir, M.; Bezzekhami, M.A.; Kouini, B.; Hassein-Bey, A.H.; Selma, T.; Amrane, A.; Imessaoudene, A.; Mouni, L. Comparative Investigation of the Effect of Eggshellpowder and Calcium Carbonate as Additivesin Eco-Friendly Polymer Drilling Fluids. Sustainability 2023, 15, 3375. [Google Scholar] [CrossRef]
- Yahoum, M.M.; Toumi, S.; Hentabli, S.; Tahraoui, H.; Lefnaoui, S.; Hadjsadok, A.; Amrane, A.; Kebir, M.; Moula, N.; Assadi, A.A. Experimental Analysis and Neural Network Modeling of the Rheological Behavior of Xanthan Gum and Its Derivatives. Materials 2023, 16, 2565. [Google Scholar] [CrossRef]
- Toumi, S.; Lekmine, S.; Touzout, N.; Moussa, H.; Elboughdiri, N.; Boudraa, R.; Benslama, O.; Kebir, M.; Danish, S.; Zhang, J. Harnessing Deep Learning for Real-Time Water Quality Assessment: A Sustainable Solution. Water 2024, 16, 3380. [Google Scholar] [CrossRef]
- Gherdaoui, D.; Yahoum, M.M.; Toumi, S.; Lekmine, S.; Lefnaoui, S.; Benslama, O.; Bouallouche, R.; Tahraoui, H.; Ola, M.S.; Ali, A. Elucidating Chiral Resolution of Aromatic Amino Acids Using Glycopeptide Selectors: A Combined Molecular Docking and Chromatographic Study. Int. J. Mol. Sci. 2024, 25, 9120. [Google Scholar] [CrossRef] [PubMed]
- Moussa, H.; Dahmoune, F.; Lekmine, S.; Mameri, A.; Tahraoui, H.; Hamid, S.; Benzitoune, N.; Moula, N.; Zhang, J.; Amrane, A. Optimization of Ultrasound-Assisted Extraction of Bioactive Compounds from Carthamus caeruleus L. Rhizome: Integrating Central Composite Design, Gaussian Process Regression, and Multi-Objective Grey Wolf Optimization Approaches. Process Biochemistry 2024, 147, 476–488. [Google Scholar] [CrossRef]
- Djeghim, H.; Bellil, I.; Benslama, O.; Lekmine, S.; Temim, E.; Boufendi, H.; Postigo, I.; Sánchez, P.; Khelifi, D. Effects of Genetic Diversity on the Allergenicity of Peanut (Arachis Hypogaea) Proteins: Identification of the Hypoallergenic Accessions Using BALB/c Mice Model and in Silico Analysis of Ara h 3 Allergen Cross-Reactivity. J. Proteomics 2024, 306, 105264. [Google Scholar] [CrossRef] [PubMed]
- Lekmine, S.; Benslama, O.; Kadi, K.; Brik, A.; Djeffali, O.; Ounissi, M.; Slimani, M.; Ola, M.S.; Eldahshan, O.A.; Martín-García, A.I. Preliminary Investigation of Astragalus Arpilobus Subsp. Hauarensis: LC-MS/MS Chemical Profiling, In Vitro Evaluation of Antioxidant, Anti-Inflammatory Properties, Cytotoxicity, and In Silico Analysis against COX-2. Antioxidants 2024, 13, 654. [Google Scholar] [CrossRef] [PubMed]
- Boussekine, S.; Lekmine, S.; Gasmi, S.; Benkhedir, A.; Saker, H.; Lidoughi, A. The Protective Effect of Selenium on Diabetic Nephropathy in Wistar Rats. J. Microbiol. Biotechnol. Food Sci. 2022, 12, e5960. [Google Scholar] [CrossRef]
- Djellal, S.; Dahmoune, F.; Aoun, O.; Remini, H.; Belbahi, A.; Dairi, S.; Moussa, H.; Lakehal, M.; Kassouar, S.; Lakhdari, C. Optimization of Ultrasound-Assisted Extraction of Galactomannan from Carob Seeds “Ceratonia siliqua L.” and Evaluation of Their Functional Properties and in Vitro Anti-Inflammatory Activity. Sep. Sci. Technol. 2024, 59, 41–58. [Google Scholar] [CrossRef]
- Hamid, S.; Oukil, N.F.; Moussa, H.; Mahdjoub, M.M.; Djihad, N.; Berrabah, I.; Bouhenna, M.M.; Chebrouk, F.; Hentabli, M. Enhancing Basil Essential Oil Microencapsulation Using Pectin/Casein Biopolymers: Optimization through D-Optimal Design, Controlled Release Modeling, and Characterization. Int. J. Biol. Macromol. 2024, 265, 130948. [Google Scholar] [CrossRef] [PubMed]

| Peak No. | S.P. Area Ratio | Mean (nm) | S.D. (nm) | Mode (nm) | Z-Average (nm) | PI | |
|---|---|---|---|---|---|---|---|
| Particle size (nm) | 1 | 0.23 | 29.6 | 2.2 | 29.5 | 111.7 | 0.320 |
| 2 | 0.77 | 130.5 | 12.9 | 129 | |||
| Total | 1 | 107.1 | 44.1 | 129 | |||
| Zeta potential | Zeta Potential mean (mV) | Electrophoretic mobility mean (cm2/Vs) | |||||
| −21.2 | −0.000164 | ||||||
| Pathogenic Bacteria | Type Strain | S. officinalis L. Extract | S. officinalis L. Extract (50 mg/mL) | SO-AgNPs | SO-AgNPs |
|---|---|---|---|---|---|
| Strains | MIC (mg/mL) | MIC (mg/mL) | (1 mg/mL) | ||
| Staphylococcus aureus | (ATCC 6538) (Food born) | N/A | Negative | N/A | 14.67 ± 0.57 |
| Escherichia coli | (ATCC 25922) | 6.25 | Negative | 15 | |
| 0.25 | |||||
| Staphylococcus epidermidis | clinical sample | 3.12 | Negative | 14.67 ± 0.57 | |
| 0.25 | |||||
| Bacillus subtilis | ATCC 6633 | N/A | Negative | 15 | |
| N/A | |||||
| Bacillus cereus | Laboratory stains | 6.25 | 18.33 ± 1.15 | 0.25 | 14.67 ± 0.57 |
| Methicillin-resistant | ATCC 43300 | 6.25 | 16.67 ± 1.52 | 0.25 | 14.67 ± 1.52 |
| staphylococcus aureus (MRSA) | |||||
| Acinetobacter baumannii | 610 | 3.12 | Negative | 0.25 | 15 |
| Pseudomonas aeruginosa | ATCC 6633 | 3.12 | 15 | 0.25 | Negative |
| Enterococcus faecalis | ATCC 29212 | N/A | 11.33 ± 0.57 | N/A | 13.33 ± 1.15 |
| Klebsiella pneumoniae | Laboratory stains | N/A | Negative | N/A | Negative |
| Salmonella spp. | Laboratory stains | N/A | 15.67 ± 2.88 | N/A | 15 ± 1 |
| Plant Extract | Metallic Nanoparticles | Microbial Strains | Antimicrobial Activity (Inhibition Zone (mm) | References |
|---|---|---|---|---|
| Symphyti radix (Boraginaceae; Sym. Radix) | AgNPs | S. aureus | 5.20 + 0.05 | [28] |
| S. epidermidis | 5.40 + 0.10 | |||
| E. coli | 4.10 + 0.20 | |||
| K. pneumoniae | 3.10 + 0.05 | |||
| P. aeruginosa | 4.60 + 0.15 | |||
| B. cereus | 4.70 + 0.01 | |||
| Salvia officinalis L. | AgNPs | S. aureus | 15.25 ± 0.25 | [29] |
| S. epidermidis | 16.75 ± 1.75 | |||
| E. coli | 10.75 ± 0.75 | |||
| P. aeruginosa | 9.5 ± 0 | |||
| Salvia officinalis L. | AgNPs | S. aureus | 24.4 ± 0.05 | [30] |
| B. cereus | 24.0 ± 0.10 | |||
| B. subtilis | 18.8 ± 0.18 | |||
| E. coli | 22.4 ± 0.03 | |||
| P. aeruginosa | 20.9 ± 0.27 | |||
| K. pneumoniae | 23.0 ± 0.14 | |||
| Eucalyptus globulus L. | AgNPs | S. aureus | 20.0 ± 0.10 | [30] |
| B. cereus | 20.4 ± 0.08 | |||
| B. subtilis | 20.0 ± 0.20 | |||
| E. coli | 19.0 ± 0.01 | |||
| P. aeruginosa | 20.1 ± 0.03 | |||
| K. pneumoniae | 21.5 ± 0.01 | |||
| Aloe fleurentinorum | AgNPs | S. Aureus | 10 | [31] |
| B. Subtilis | 7 | |||
| E. Coli | 18 | |||
| Hyssopus officinalis (Hyssopus) | AgNPs | S. aureus | 14.50 ± 0.15 | [32] |
| S. epidermidis | 16.50 ± 0.10 | |||
| E. coli | 12.50 ± 0.10 | |||
| K. pneumoniae | 10.40 ± 0.10 | |||
| P. aeruginosa | 10.00 ± 0.90 | |||
| B. cereus | 9.50 ± 0.10 | |||
| E. faecalis | 10.00 ± 0.50 | |||
| Calendula officinalis | AgNPs | S. aureus | 15.10 ± 0.10 | [32] |
| S. epidermidis | 12.50 ± 0.10 | |||
| E. coli | 10.50 ± 0.35 | |||
| K. pneumoniae | 10.00 ± 0.10 | |||
| P. aeruginosa | 10.00 ± 0.10 | |||
| B. cereus | 11.80 ± 0.55 | |||
| E. faecalis | 10.40 ± 0.50 |
Disclaimer/Publisher’s Note: The statements, opinions and data contained in all publications are solely those of the individual author(s) and contributor(s) and not of MDPI and/or the editor(s). MDPI and/or the editor(s) disclaim responsibility for any injury to people or property resulting from any ideas, methods, instructions or products referred to in the content. |
© 2024 by the authors. Licensee MDPI, Basel, Switzerland. This article is an open access article distributed under the terms and conditions of the Creative Commons Attribution (CC BY) license (https://creativecommons.org/licenses/by/4.0/).
Share and Cite
Moussa, H.; Hamid, S.; Mameri, A.; Lekmine, S.; Tahraoui, H.; Kebir, M.; Touzout, N.; Dahmoune, F.; Ola, M.S.; Zhang, J.; et al. From Green Chemistry to Healthy Environments: Silver Nanoparticles as a Dual Antioxidant and Antibacterial Agents for Advancing Biomedicine and Sustainable Wastewater Treatment. Bioengineering 2024, 11, 1205. https://doi.org/10.3390/bioengineering11121205
Moussa H, Hamid S, Mameri A, Lekmine S, Tahraoui H, Kebir M, Touzout N, Dahmoune F, Ola MS, Zhang J, et al. From Green Chemistry to Healthy Environments: Silver Nanoparticles as a Dual Antioxidant and Antibacterial Agents for Advancing Biomedicine and Sustainable Wastewater Treatment. Bioengineering. 2024; 11(12):1205. https://doi.org/10.3390/bioengineering11121205
Chicago/Turabian StyleMoussa, Hamza, Sarah Hamid, Amal Mameri, Sabrina Lekmine, Hichem Tahraoui, Mohammed Kebir, Nabil Touzout, Farid Dahmoune, Mohammad Shamsul Ola, Jie Zhang, and et al. 2024. "From Green Chemistry to Healthy Environments: Silver Nanoparticles as a Dual Antioxidant and Antibacterial Agents for Advancing Biomedicine and Sustainable Wastewater Treatment" Bioengineering 11, no. 12: 1205. https://doi.org/10.3390/bioengineering11121205
APA StyleMoussa, H., Hamid, S., Mameri, A., Lekmine, S., Tahraoui, H., Kebir, M., Touzout, N., Dahmoune, F., Ola, M. S., Zhang, J., & Amrane, A. (2024). From Green Chemistry to Healthy Environments: Silver Nanoparticles as a Dual Antioxidant and Antibacterial Agents for Advancing Biomedicine and Sustainable Wastewater Treatment. Bioengineering, 11(12), 1205. https://doi.org/10.3390/bioengineering11121205

